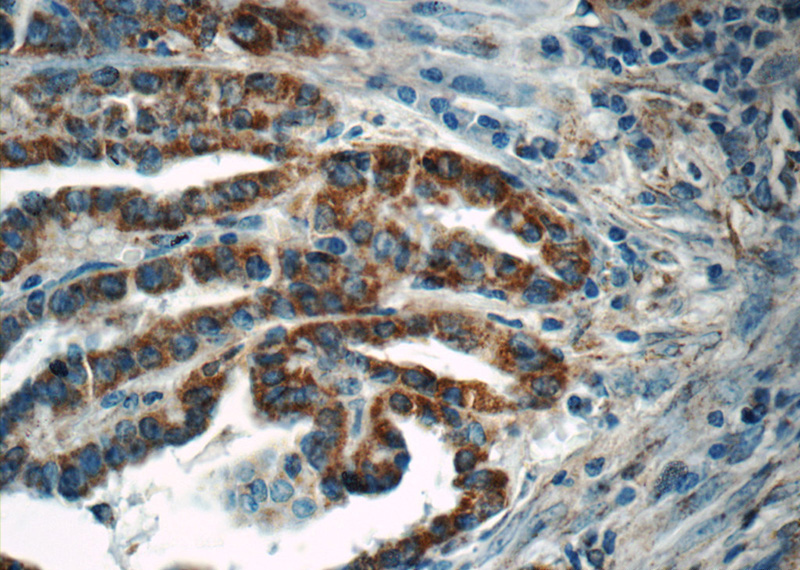
Immunohistochemistry of paraffin-embedded human thyroid cancer tissue slide using Catalog No:107823(ACAA1 Antibody) at dilution of 1:50 (under 40x lens)

-
Product Name
ACAA1 antibody
- Documents
-
Description
ACAA1 Rabbit Polyclonal antibody. Positive WB detected in L02 cells, A549 cells, human lung tissue. Positive IF detected in HeLa cells. Positive IHC detected in human thyroid cancer tissue, human liver cancer tissue, human prostate cancer tissue. Observed molecular weight by Western-blot: 41 kDa
-
Tested applications
ELISA, WB, IF, IHC
-
Species reactivity
Human,Mouse,Rat; other species not tested.
-
Alternative names
ACAA antibody; ACAA1 antibody; Acetyl CoA acyltransferase antibody; Beta ketothiolase antibody; PTHIO antibody; THIO antibody
-
Isotype
Rabbit IgG
-
Preparation
This antibody was obtained by immunization of ACAA1 recombinant protein (Accession Number: NM_001607). Purification method: Antigen affinity purified.
-
Clonality
Polyclonal
-
Formulation
PBS with 0.1% sodium azide and 50% glycerol pH 7.3.
-
Storage instructions
Store at -20℃. DO NOT ALIQUOT
-
Applications
Recommended Dilution:
WB: 1:500-1:5000
IHC: 1:20-1:200
IF: 1:10-1:100
-
Validations

L02 cells were subjected to SDS PAGE followed by western blot with Catalog No:107823(ACAA1 antibody) at dilution of 1:1000

Immunohistochemistry of paraffin-embedded human thyroid cancer tissue slide using Catalog No:107823(ACAA1 Antibody) at dilution of 1:50 (under 10x lens)
Immunohistochemistry of paraffin-embedded human thyroid cancer tissue slide using Catalog No:107823(ACAA1 Antibody) at dilution of 1:50 (under 40x lens)

Immunofluorescent analysis of HeLa cells using Catalog No:107823(ACAA1 Antibody) at dilution of 1:25 and Rhodamine-Goat anti-Rabbit IgG
-
Background
ACAA1 represents acetyl-Coenzyme A acyltransferase 1
-
References
- Krause C, Rosewich H, Woehler A, Gärtner J. Functional analysis of PEX13 mutation in a Zellweger syndrome spectrum patient reveals novel homooligomerization of PEX13 and its role in human peroxisome biogenesis. Human molecular genetics. 22(19):3844-57. 2013.
- Kassmann CM, Quintes S, Rietdorf J. A role for myelin-associated peroxisomes in maintaining paranodal loops and axonal integrity. FEBS letters. 585(14):2205-11. 2011.
- Richert S, Kleinecke S, Günther J. In vivo labeling of peroxisomes by photoconvertible mEos2 in myelinating glia of mice. Biochimie. 98:127-34. 2014.
Related Products / Services
Please note: All products are "FOR RESEARCH USE ONLY AND ARE NOT INTENDED FOR DIAGNOSTIC OR THERAPEUTIC USE"
